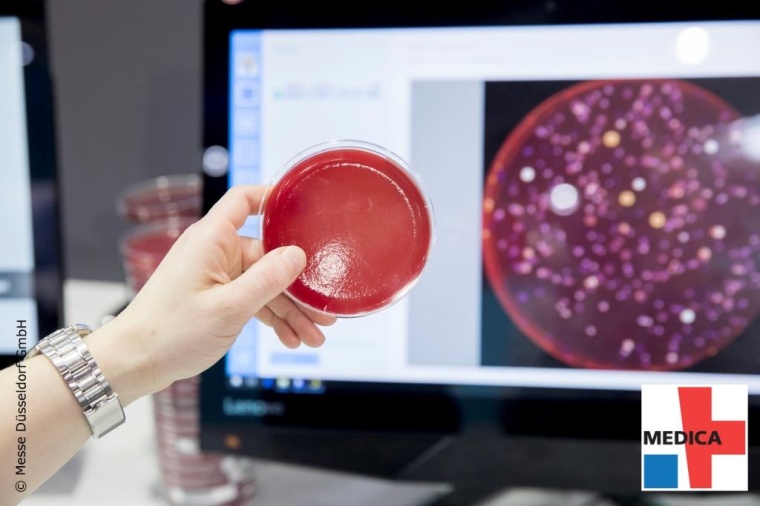
Digitalisierung von Zellkulturbildern auf der Medica (Foto: Messe Düsseldorf...

Von der Laborbank an den Heimarbeitsplatz - die Digitalisierung eröffnet neue Möglichkeiten

Wie können Präparate digitalisiert und damit zugänglich gemacht werden für den Einsatz Künstlicher Intelligenz? Und lassen sich Arbeitsprozesse der Pathologie künftig sogar von Heimarbeitsplätzen aus realisieren? Zumindest die erste Frage findet zwar noch nicht durch gelebte Realität Beantwortung, rein technisch betrachtet scheint sie aber gelöst: „Digitalisierung der Pathologie – vollumfänglicher, elektronischer Workflow mit allen fallrelevanten histologischen Objektträgern zur digitalen und damit ortsunabhängigen Befundung“ lautet jedenfalls der Name eines der fünf „Schlüsselprojekte“, die beim diesjährigen Projektzyklus der Digitalisierungsinitiative Entscheiderfabrik behandelt und im Rahmen der weltführenden Medizinmesse Medica in Düsseldorf im November am 19. November vorgestellt werden (Medica 2019: 18. – 21. November).
Dass sich die Entscheiderfabrik auch der Pathologie widmet, hängt mit den Potenzialen zusammen, die sich aus der Digitalisierung für diesen Bereich ergeben. Der Alltag von Pathologen besteht aus der mikroskopischen Beurteilung von Gewebe sowie vielfach auch hochmoderner molekularer Krebsdiagnostik. Obwohl der Fachbereich in den letzten Jahren durch Highend-Technologien wie `Next-Generation-Sequencing´ und weitere molekulare Analysen seinen Stellenwert als Wegweiser moderner Krebstherapie beweisen konnte, so bleibt dies zumindest in Deutschland eine Disziplin mit geringem Digitalisierungsgrad.
Das soll zukünftig geändert werden: „Verfahren der Künstlichen Intelligenz, die für eine Diagnostik in Frage kommen, setzen voraus, dass die Schnittpräparate digital vorliegen“, erklärt Professor Reinhard Büttner, Leiter des Instituts für Pathologie am Universitätsklinikum Köln. Im Labor hergestellte Objektträger können heute mit Hilfe eines Slide-Scanners digitalisiert werden. Dies benötigt etwa rund dreißig Sekunden pro Objektträger. Die dabei entstehenden Bilddatenmengen nehmen ca. drei Gigabyte pro Objektträger im DICOM-Format in Anspruch und werden auf Basis eines „Pathologie-PACS“ in einem digitalen Bildmanagementsystem gespeichert. Aus dem IT-Verwaltungssystem der Pathologie bzw. des Labors werden die Bilder des zu befundenen Falls auf Anforderung des Arztes automatisch geöffnet. Der Arzt führt die Befundung am Monitor durch, und er diktiert den Befund in seinem IT-System.
Die Digitalisierung ermöglicht zukünftig also verteilte Workflows mit flexibler Personalplanung sowie eine ortsunabhängige Befundung insbesondere bei Schnellschnitten ohne Transport durch Taxis. Letztendlich könnte die Digitalisierung der Pathologie der Einrichtung von Heimarbeitsplätzen und der Versorgung entfernter Standorte dienen.
Weitere Informationen zum Programm der Entscheiderfabrik sind hier erhältlich.
Meist gelesen

Helga-Reifert-Preis für Krebsforschung
Dr. Johannes Falter und Dr. Benedikt Wagner vom Universitätsklinikum Regensburg erhielten für ihre Krebsforschung den Helga-Reifert-Preis.

Wicker-Kliniken stellen neurologische Versorgung in Bad Zwesten und Bad Wildungen neu auf
Die Wicker-Kliniken stellen ihre neurologische Versorgung für die Zukunft auf: Im ersten Quartal 2026 wird der Krankenhausbereich der Hardtwaldklinik I in Bad Zwesten – mit neurologischer Akutklinik (Phase A), neurologischer Frührehabilitation (Phase B), MS-Ambulanz und Radiologie – an die Werner Wicker Klinik in Bad Wildungen verlagert. Der Rehabereich bleibt am Standort und wird ausgebaut.

Dedalus auf Platz 1 der „2026 Best in KLAS: Software & Services”
Die Dedalus Group verteidigt ihre Spitzenposition als bester Anbieter im Ranking „2026 Best in KLAS: Software & Services für elektronische Gesundheitsakten.

Krankenhäuser bereit für Rückkehr des Zivildienstes
Die deutschen Krankenhäuser wären bereit, erneut Zivildienstleistende zu beschäftigen und ihnen die Möglichkeit einzuräumen, im Falle einer Wiedereinführung ihren Dienst in Kliniken zu leisten.

Neuer operativer Geschäftsführer und neue Pflegedirektion am Klinikum Frankfurt (Oder)
Das Klinikum Frankfurt (Oder) verstärkt seine Führungsspitze. Christopher Arndt (37) wird zum 1. März 2026 zum operativen Geschäftsführer des Klinikums Frankfurt (Oder) bestellt.










